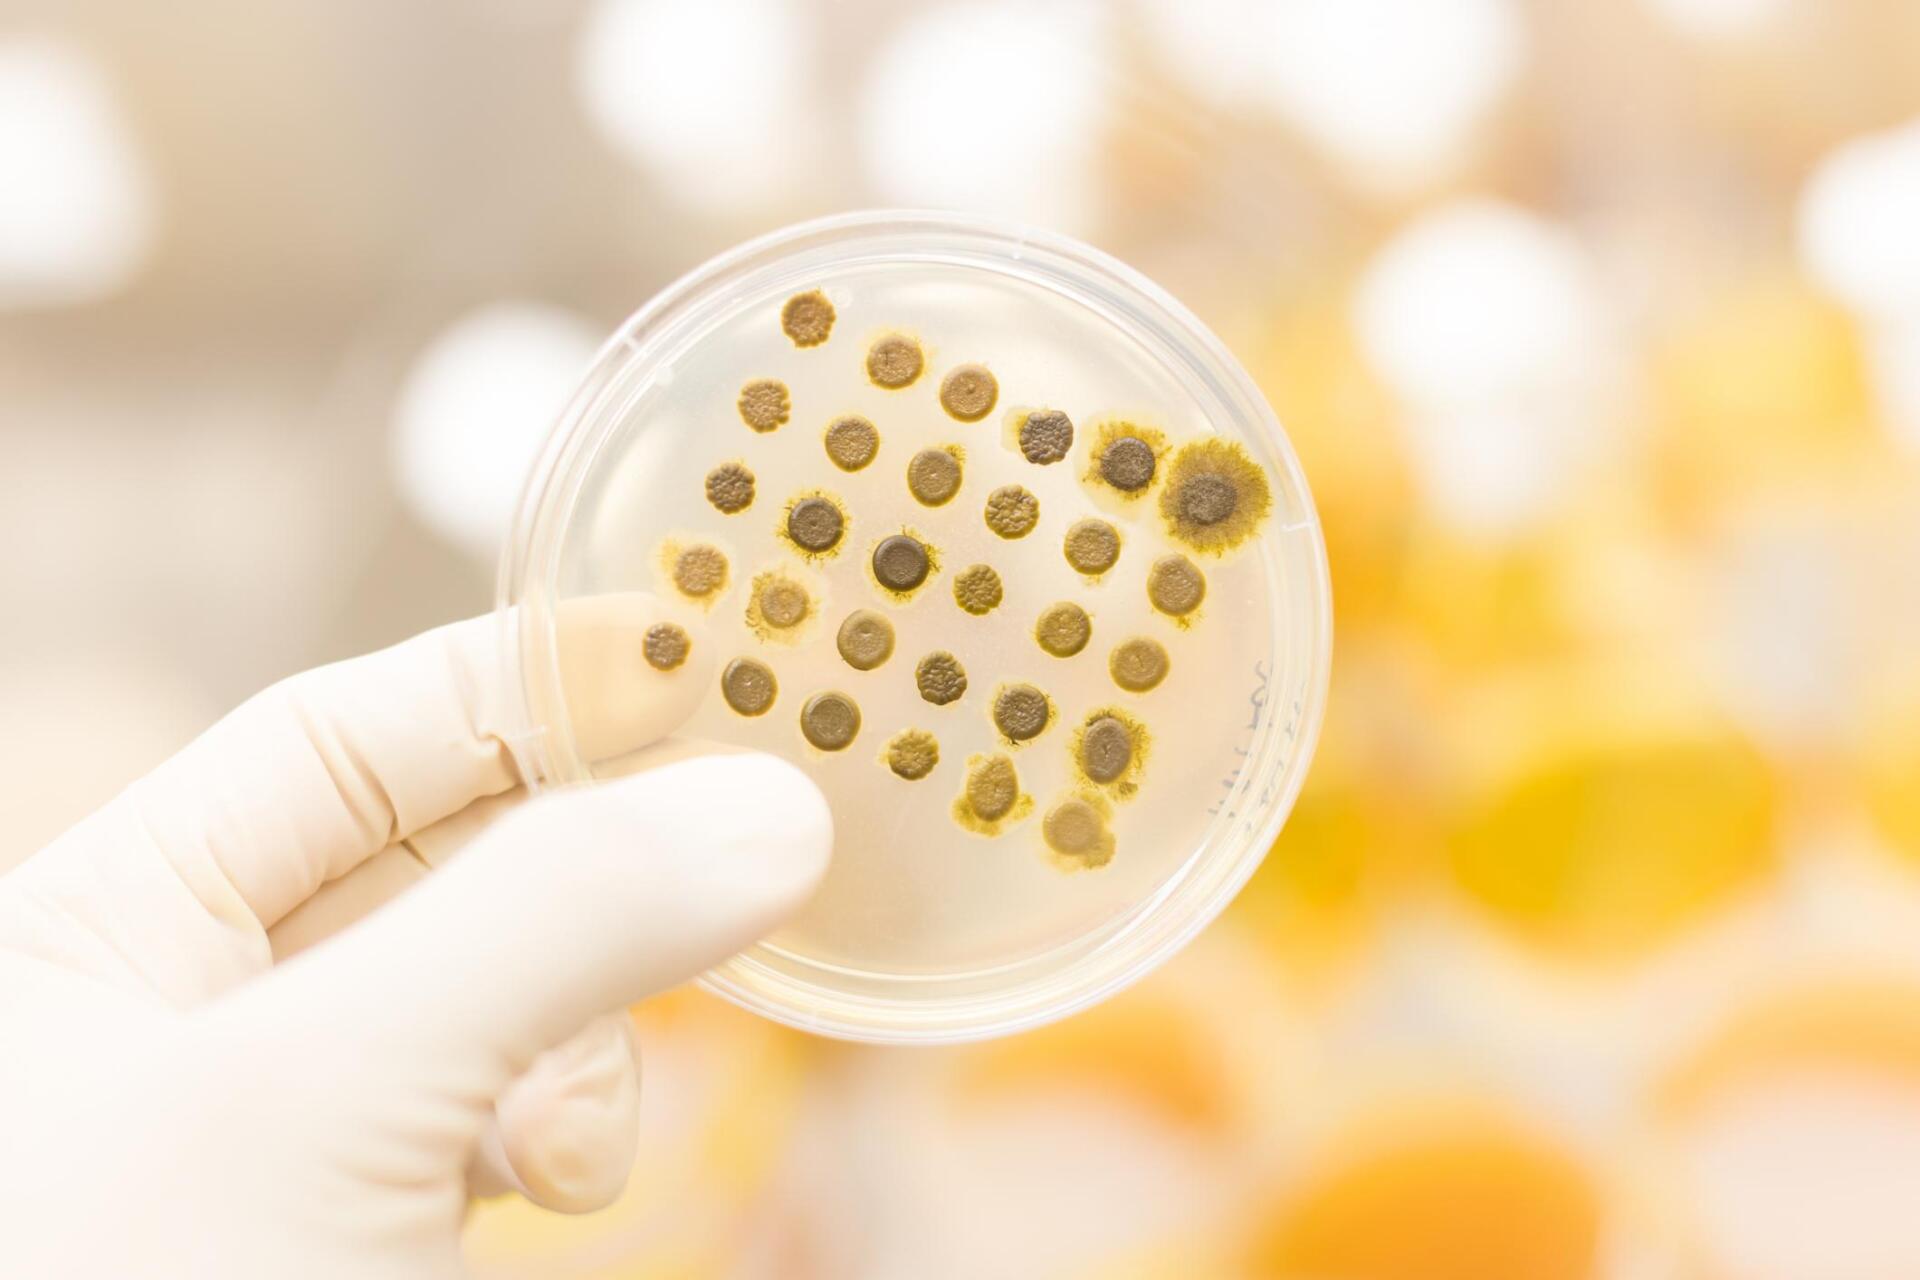
different types of mold

Grand Rapids Mold Relief
Locally owned and operated, we serve the entire Grand Rapids area.
Mold Removal & Remediation in Grand Rapids, MI

Mold Removal and Remediation Process
01
Mold Inspection
The first step is to conduct a mold inspection. This will help us determine the extent of the mold problem, and it will also allow us to develop a plan of action.
02
Mold Testing
Once the mold inspection is complete, we will then proceed to mold testing. This will help us identify the type of mold that is present in your home or office.
03
Mold Removal
Once we have identified the type of mold, we will then begin the mold removal process. This involves using a variety of techniques and products to safely and effectively remove mold from your property.
04
Mold Prevention
After the mold has been removed, we will then take the necessary steps to prevent it from coming back. This includes making sure that your property is properly ventilated and that you are using mold-resistant products.
Our Services
When it comes to having mold problems in your home, it is never too early to get ahead of the problem and call in professionals to evaluate the situation. The reality of the matter is that mold spreads, and if left unchecked, mold can cause serious damage to your home. Not only can mold damage your belongings, but it can also cause health problems for you and your family which is why we provide advice on mold cleanup and mold removal as soon as possible.
Mold Removal
If you have noticed mold starting to grow in specific areas of your home, it is important to take action as soon as possible. If mold has just started to grow, we may be able to remove it with a simple cleaning solution. However, if mold has spread throughout your home, a more thorough mold removal process will be necessary. Our professional mold removal team at Grand Rapids Mold Relief will come to your home and assess the mold situation. We will then develop a mold removal plan that is tailored to your specific needs.
Types of Mold
Many people think that if you have mold in your home that it is all the same. This could not be further from the truth. There are many different types of mold, and each type is unique. The most common types of mold that we see in homes are black mold, white mold, and green mold. Black mold is the most dangerous type of mold and can cause health problems for you and your family. White mold is not as dangerous as black mold but can still cause damage to your home. Green mold is the least dangerous type of mold but can still cause problems if left unchecked. Each type is unique and requires a different mold removal plan. That is why it is so important to have a mold removal company that knows what they are doing. Our team of experts can identify the type of mold in your home and develop a plan to remove it.
Mold Exposure
If you have mold in your home, it is important to be aware of the health risks that come with mold exposure. Mold can cause a wide range of health problems, including respiratory problems, headaches, and dizziness. It is important to take action as soon as possible to protect your health. Our team of experts can safely and effectively remove mold from your home so that you can rest assured knowing that your family is safe.
Mold Inspections & Testing
If you are concerned that mold might be growing in your home, the best thing to do is call in a professional for a mold inspection. A mold inspection will help to identify whether or not mold is present in your home. Mold testing will also be performed to determine the type of mold that is present. Our team of experts can perform mold inspections and mold testing to help you get started on the path to a mold-free home.
Common signs you have a mold problem in your home
Inhaling mold spores can be incredibly dangerous for anyone, but it is especially dangerous for young children, the elderly, and people with weakened immune systems. If you think you might have a mold problem in your home, there are some common signs that you can look for:
If you are experiencing any of these signs, it is important to call in professionals for a mold inspection. Our team can help you identify the mold problem in your home and develop a plan to remove it. Call us today!
Musty Odors
One of the most common signs of mold is a musty odor. If you notice a musty smell in your home, it is a good idea to call in professionals for a mold inspection.
Visible Mold
Another common sign of mold is visible mold growth. If you see mold growing in your home, it is important to call in professionals to remove the mold.
Water Damage
Water damage is one of the most common causes of mold. If you have had water damage in your home, it is important to call in professionals for a mold inspection.
Health Problems
If you or someone in your family is experiencing unexplained health problems, it could be due to mold exposure. If you think mold might be the cause of your health problems, it is important to call in professionals for a mold inspection.
Common places mold could be hiding in your home
Mold can grow anywhere in your home where there is moisture. Mold loves dark, damp places. Here are some of the most common places that mold hides:

Bathrooms
Bathrooms are one of the most common places for mold to grow because they are often moist. If you have mold in your bathroom, it is important to call in professionals for mold removal.
Basements
Basements are often known to have mold growth because they can be dark and damp. If you have mold in your basement, it is important to call in professionals for an assesment.
Kitchens
Kitchens are another common place for mold to grow because they are often moist. If you have mold in your kitchen, it is important to call in professionals for help.
Attics
Mold commonly grows in attics because they are dark and often overlooked spaces. If you suspect there is mold growing in your attic, call the experts for an inspection right away.
FAQs
Got a question? We’re here to help.
To Prevent Mold Growth in Your Home
Mold can be a serious problem in your home if it is not prevented. Here are some tips to prevent mold growth in your home:
- Keep the humidity level in your home low. Mold thrives in humid environments.
- Fix any leaks as soon as possible. Leaks are one of the most common causes of mold.
- Keep your home clean and free of clutter. Mold loves to grow in dirty, cluttered environments.
- Make sure your home is well ventilated. Ventilation helps to prevent mold growth by allowing air to circulate.
If you follow these tips, you can help to prevent mold growth in your home.
We are here to help you every step of the way.When it comes to mold, it is important to trust the experts.
At Grand Rapids Mold Relief, we have years of experience in mold remediation and removal. We know how to safely remove mold from your home or business. We also offer a wide range of other services, including mold inspections and mold testing.
Contact us today to learn more about our services.
"Trust the Experts at Grand Rapids Mold Relief"
Book An Appointment Today
As you can probably tell by now, we are very serious about what we do here, because we are serious about keeping your home a safe and healthy place. This is why you can be sure that choosing the services that we offer is the right choice for your home. Contact us to discuss your needs.